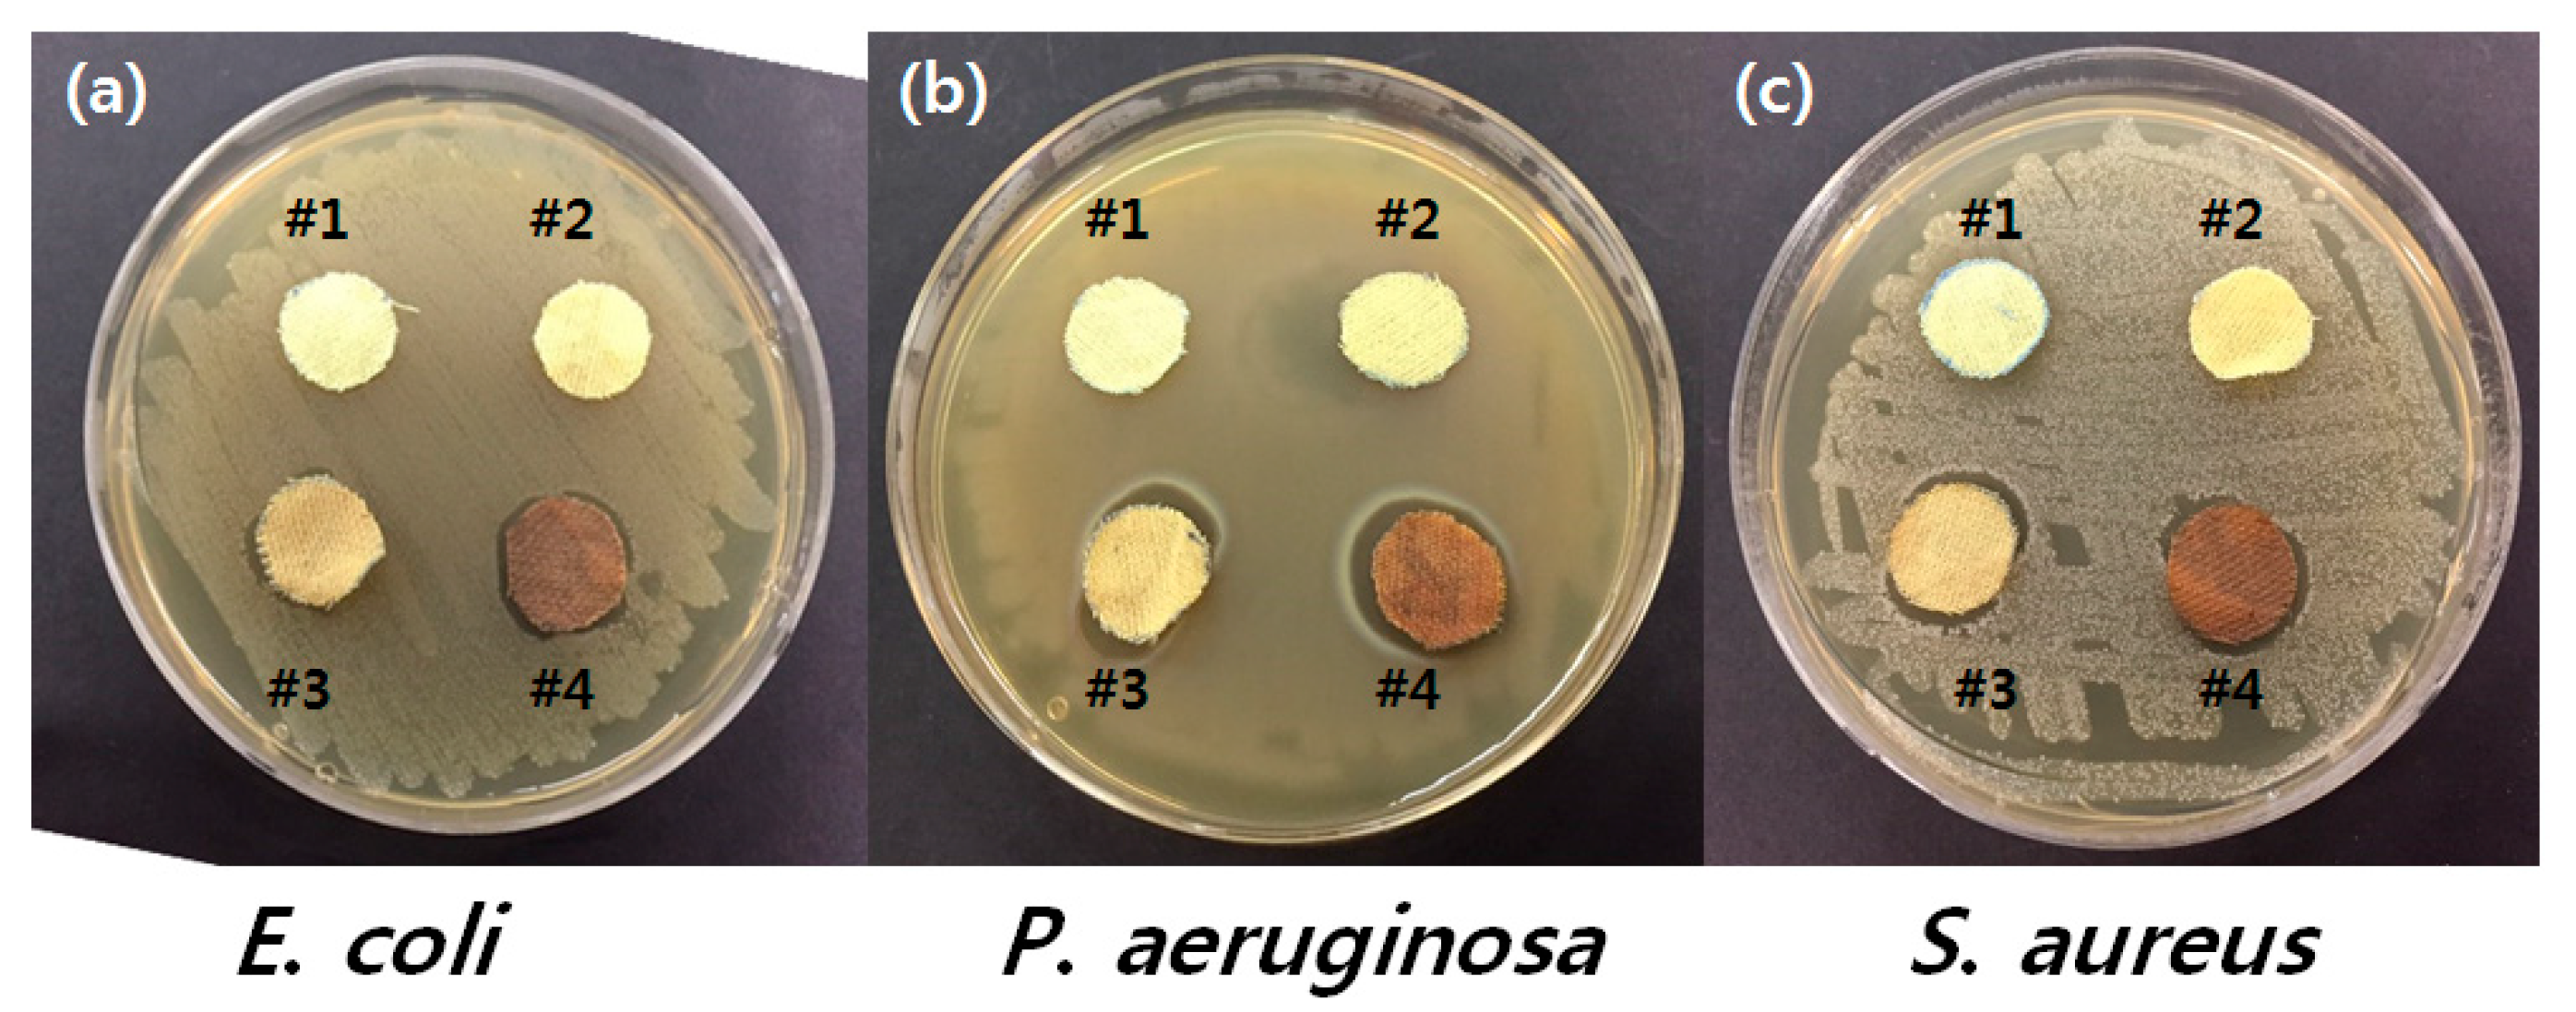
Polymers 09 00357 g006 550

Development of Synergistic Antimicrobial Coating of p-Aramid Fibers Using Ag Nanoparticles and Glycidyltrimethylammonium Chloride (GTAC) without the Aid of a Cross-Linking Agent
Abstract
:1. Introduction
2. Materials and Methods
2.1. Materials
2.2. Manufacture of QAS Treated p-Aramid Fibers
2.3. Manufacture of AgNPs-Coated p-Aramid Fibers
2.4. Transmission Electron Microscope (TEM)
2.5. Scanning Electron Microscope-Energy Dispersive Spectroscopy (SEM-EDS)
2.6. Washing Fastness
2.7. Tensile Strength
2.8. Thermogravimetric Analysis (TGA)
2.9. Antimicrobial Activity Analysis
3. Results and Discussion
3.1. Surface Analysis of GTAC- and AgNPs-Treated Samples
3.2. Physical and Thermal Properties
3.3. Durability and Antimicrobial Efficacy
4. Conclusions
Acknowledgments
Author Contributions
Conflicts of Interest
References
- Manyukov, E.A.; Sadova, S.F.; Baeva, N.N.; Platonov, V.A. Study of dying of thermostable para/meta-aramid fibre. Fibre Chem. 2005, 37, 54–58. [Google Scholar] [CrossRef]
- Hongu, T.; Phillips, G.O. New Fibers, 1st ed.; Woodheading Publishing: Cambridge, UK, 1997; pp. 35–43. [Google Scholar]
- Busseron, E.; Ruff, Y.; Moulin, E.; Giuseppone, N. Supramolecular self-assemblies as functional nanomaterials. Nanoscale 2013, 5, 7098–7140. [Google Scholar] [CrossRef] [PubMed]
- Morgan, R.J.; Pruneda, C.O.; Steele, W.J. The relationship between the physical structure and the microscopic deformation and failure processes of poly(p-phenylene terephthalamide) fibers. J. Polym. Sci. B 1983, 21, 1757–1783. [Google Scholar] [CrossRef]
- Li, G.; Zhang, C.; Wang, Y.; Li, P.; Yu, Y.; Jia, X.; Liu, H.; Yang, X.; Xue, Z.; Ryu, S. Interface correlation and toughness matching of phosphoric acid functionalized Kevlar fiber and epoxy matrix for filament winding composites. Compos. Sci. Technol. 2008, 68, 3208–3214. [Google Scholar] [CrossRef]
- O’Connor, I.; Hayden, H.; O’Connor, S.; Coleman, J.N.; Gun’ko, Y.K. Polymer reinforcement with Kevlar-coated carbon nanotubes. J. Phys. Chem. C 2009, 113, 20184–20192. [Google Scholar] [CrossRef]
- Atanasov, S.E.; Oldham, C.J.; Slusarski, K.A.; Taggart-Scarff, J.; Sherman, S.A.; Senecal, K.J.; Filocamo, S.F.; McAllister, Q.P.; Wetzel, E.D.; Parsons, G.N. Improved cut-resistance of Kevlar using controlled interface reactions during atomic layer deposition of ultrathin(<50 Å) inorganic coatings. J. Mater. Chem. A 2014, 2, 17371–17379. [Google Scholar]
- Ferrero, F.; Tonetti, C.; Periolatto, M. Adsorption of chromate and cupric ions onto chitosan-coated cotton gauze. Carbohydr. Polym. 2014, 110, 367–373. [Google Scholar] [CrossRef] [PubMed]
- Wu, Z.; Wu, J.; Reng, T.; Li, Y.; Lin, D.; Xing, B.; Li, C.; Yang, Y.; Yang, L.; Zhang, L.; et al. Preparation and application of starch/polyvinyl alcohol/citric acid ternary blend antimicrobial functional food packing films. Polymers 2017, 9, 102. [Google Scholar] [CrossRef]
- Maryan, A.S.; Montazer, M.; Harifi, T. Synthesis of nano silver on cellulosic denim fabric producing yellow colored garment with antibacterial properties. Carbohydr. Polym. 2015, 115, 568–574. [Google Scholar] [CrossRef] [PubMed]
- Scaffaro, R.; Maio, A.; Lopresti, F.; Botta, L. Nanocarbons in electrospun polymeric nanomats for tissue engineering: A review. Polymers 2017, 9, 76. [Google Scholar] [CrossRef]
- Teli, M.D.; Sheikh, J. Modified bamboo rayon-copper nanoparticle composites as antibacterial textiles. Int. J. Biol. Macromol. 2013, 61, 302–307. [Google Scholar] [CrossRef] [PubMed]
- Rodriguez, C.; Di Cara, A.; Renaud, F.N.R.; Freney, J.; Horvais, N.; Borel, R.; Puzenat, E.; Guillard, C. Antibacterial effects of photocatalytic textiles for footwear application. Catal. Today 2014, 230, 41–46. [Google Scholar] [CrossRef]
- Pour, S.Z.; Makvandi, P.; Ghaemy, M. Performance properties and antibacterial activity of crosslinked films of quaternary ammonium modified starch and poly(vinyl alcohol). Int. J. Biol. Macromol. 2015, 80, 596–604. [Google Scholar] [CrossRef] [PubMed]
- Pelgrift, R.Y.; Friedman, A.J. Nanotechnology as a therapeutic tool to combat microbial resistance. Adv. Drug Deliv. Rev. 2013, 65, 1803–1815. [Google Scholar] [CrossRef] [PubMed]
- Stoimenov, P.K.; Klinger, R.L.; Marchin, G.L.; Klabunde, K.J. Metal oxide nanoparticles as bactericidal agents. Langmuir 2002, 18, 6679–6686. [Google Scholar] [CrossRef]
- Brayner, R.; Ferrari-Iliou, R.; Brivois, N.; Djediat, S.; Benedetti, M.F.; Fiévet, F. Toxicological impact studies based on Escherichia bacteria in ultrafine ZnO nanoparticles colloidal medium. Nano Lett. 2006, 6, 866–870. [Google Scholar] [CrossRef] [PubMed]
- Applerot, G.; Lipovsky, A.; Dror, R.; Perkas, N.; Nitzan, Y.; Lubart, R.; Gedanken, A. Enhanced antibacterial activity of nanocrystalline ZnO due to increased ROS-mediated cell injury. Adv. Funct. Mater. 2009, 19, 842–852. [Google Scholar] [CrossRef]
- Rozenzhak, S.M.; Kadakia, M.P.; Caserta, T.M.; Westbrook, T.R.; Stone, M.O.; Naik, R.R. Cellular internalization and targeting of semiconductor quantum dots. Chem. Commun. 2005, 17, 2217–2219. [Google Scholar] [CrossRef] [PubMed]
- Hebeish, A.; El-Naggar, M.E.; Fouda, M.M.G.; Ramadan, M.A.; Al-Deyab, S.S.; El-rafie, M.H. Highly effective antibacterial textiles containing green synthesized silver nanoparticles. Carbohydr. Polym. 2011, 86, 936–940. [Google Scholar] [CrossRef]
- Jeong, S.H.; Hwang, Y.H.; Yi, S.C. Antibacterial properties of padded PP/PE nonwovens incorporating nano-sized silver colloids. J. Mater. Sci. 2005, 40, 5413–5418. [Google Scholar] [CrossRef]
- Petkova, P.; Francesko, A.; Prelshtein, I.; Gedanken, A.; Tzanov, T. Simultaneous sonochemical-enzymatic coating of medical textiles with antibacterial ZnO nanoparticles. Ultrason. Sonochem. 2016, 29, 244–250. [Google Scholar] [CrossRef] [PubMed]
- Silver, S.; Phung, L.T. Bacterial heavy metal resistance: New surprises. Annu. Rev. Microbiol. 1996, 50, 753–789. [Google Scholar] [CrossRef] [PubMed]
- Sharma, V.K.; Yngard, R.A.; Lin, Y. Silver nanoparticles: Green synthesis and their antimicrobial activities. Adv. Colloid Interface Sci. 2009, 145, 83–96. [Google Scholar] [CrossRef] [PubMed]
- Tamayo, L.; Azócar, M.; Kogan, M.; Riveros, A.; Páez, M. Copper-polymer nanocomposites: An excellent and cost-effective biocide for use on antibacterial surfaces. Mater. Sci. Eng. C 2016, 69, 1391–1409. [Google Scholar] [CrossRef] [PubMed]
- Montazer, M.; Alimohammadi, F.; Shamei, A.; Rahimi, M. Durable antibacterial and cross-linking cotton with colloidal silver nanoparticles and butane tetracarboxylic acid without yellowing. Colloids Surf. B 2012, 89, 196–202. [Google Scholar] [CrossRef] [PubMed]
- Tang, C.; Hu, D.; Cao, Q.; Yan, W.; Xing, B. Silver nanoparticles-loaded activated carbon fibers using chitosan as binding agent: Preparation, mechanism, and their antibacterial activity. Appl. Surf. Sci. 2017, 394, 457–465. [Google Scholar] [CrossRef]
- Kim, S.S.; Park, J.E.; Lee, J. Properties and antimicrobial efficacy of cellulose fiber coated with silver nanoparticles and 3-mercaptopropyltrimethoxysilane (3-MPTMS). J. Appl. Polym. Sci. 2011, 119, 2261–2267. [Google Scholar] [CrossRef]
- Sendroiu, I.E.; Warner, M.E.; Corn, R.M. Fabrication of silica-coated gold nanorods functionalized with DNA for enhanced SPR imaging biosensing applications. Langmuir 2009, 25, 11282–11284. [Google Scholar] [CrossRef] [PubMed]
- Wu, J.; Xie, J.; Ling, L.; Ma, G.; Wang, B. Surface modification of nanosilica with 3-mercaptopropyl trimethoxysilane and investigation of its effect on the properties of UV curable coatings. J. Coat. Technol. Res. 2013, 10, 849–857. [Google Scholar] [CrossRef]
- Chen, X.; Cai, K.; Fang, J.; Lai, M.; Li, J.; Hou, Y.; Luo, Z.; Hu, Y.; Tang, L. Dual action antibacterial TiO2 nanotubes incorporated with silver nanoparticles and coated with a quaternary ammonium salt (QAS). Surf. Coat. Technol. 2013, 216, 158–165. [Google Scholar] [CrossRef]
- Gottenbos, B.; van der Mei, H.; Klatter, F.; Nieuwenhuis, P.; Busscher, H. In vitro and in vivo antimicrobial activity of covalently coupled quaternary ammonium silane coating on silicon rubber. Biomaterials 2002, 23, 1417–1423. [Google Scholar] [CrossRef]
- Thomas, J.J.; Rekha, M.R.; Sharma, C.P. Dextran-glycidyltrimethylammonium chloride conjugate/DNA nanoplex: A potential non-viral and haemocompatible gene delivery system. Int. J. Pharm. 2010, 389, 195–216. [Google Scholar] [CrossRef] [PubMed]
- Sajjan, A.M.; Kumar, B.K.J.; Kittur, A.A.; Kariduraganavar, M.Y. Development of novel grafted hybrid PVA membranes using glycidyltrimethylammonium chloride for pervaporation separation of water-isopropanol mixtures. J. Ind. Eng. Chem. 2013, 19, 427–437. [Google Scholar] [CrossRef]
- Kang, C.; Kim, S.S.; Kim, S.; Lee, J.; Lee, J.; Roh, C.; Lee, J. Antibacterial cotton fibers treated with silver nanoparticles and quaternary ammonium salts. Carbohydr. Polym. 2016, 15, 1012–1018. [Google Scholar] [CrossRef] [PubMed]
- Jang, M.; Bae, S.; Lee, S.; Lee, Y.; Hwang, Y. Effect of material properties on stability of silver nanoparticles in water. J. Nanosci. Nanotechnol. 2014, 14, 9665–9669. [Google Scholar] [CrossRef] [PubMed]
- Eremenko, A.M.; Petrik, I.S.; Smirnova, N.P.; Rudenko, A.V.; Marikvas, Y.S. Antibacterial and antimycotic activity of cotton fabrics, impregnated with silver and binary silver/copper nanoparticles. Nanoscale Res. Lett. 2016, 11, 28. [Google Scholar] [CrossRef] [PubMed]
- Roh, C.; Lee, J.; Kinger, M.; Kang, C. In vitro studies on a microfluidic sensor with embedded obstacles using new antibacterial synthetic compounds (1-TDPPO) mixed prop-2-en-1-one with difluoro phenyl. Sensors 2017, 17, 803. [Google Scholar] [CrossRef] [PubMed]
- Wang, W.; Jiang, T.; Zhang, W.; Li, C.; Chen, Y. Predictors of mortality in bloodstream infections caused by multidrug-resistant gram-negative bacteria: 4 years of collection. Am. J. Infect. Control 2017, 45, 59–64. [Google Scholar] [CrossRef] [PubMed]

| Control (Treated with Distilled Water) | Treated with GTAC (10 wt %) | Treated with AgNPs (30,000 ppm) | Treated with GTAC (10 wt %)/AgNPs (30,000 ppm) |
|---|---|---|---|
| 33.06 ± 0.69 | 26.75 ± 1.40 | 27.23 ± 1.23 | 26.23 ± 0.84 |
| Washing (Cycles) | Ag (Atomic %) | Retention (%) |
|---|---|---|
| 0 | 0.79 | 100 |
| 1 | 0.63 | 79.75 |
| 2 | 0.48 | 60.76 |
| 3 | 0.42 | 53.16 |
| 4 | 0.33 | 41.77 |
| 5 | 0.27 | 34.18 |
| Samples | Bacterial No. (cfu/Sample) | ||
|---|---|---|---|
| Escherichia coli a | Pseudomonas aeruginosa b | Staphylococcus aureus c | |
| Untreated p-aramid (# 1) | 2.9 × 105 | 4.2 × 105 | 1.34 × 105 |
| p-aramid treated with GTAC (# 2) | 1.18 × 102 | 4.65 × 103 | 5.05 × 102 |
| p-aramid treated with AgNPs (# 3) | 0 | 1.7 × 102 | 3.24 × 103 |
| p-aramid treated with GTAC/AgNPs (# 4) | 0 | 0 | 0 |
| p-aramid treated with GTAC/AgNPs after 5 washing cycles | 0 | 0 | 0 |
© 2017 by the authors. Licensee MDPI, Basel, Switzerland. This article is an open access article distributed under the terms and conditions of the Creative Commons Attribution (CC BY) license (http://creativecommons.org/licenses/by/4.0/).
Share and Cite
Kang, C.; Ahn, D.; Roh, C.; Kim, S.S.; Lee, J. Development of Synergistic Antimicrobial Coating of p-Aramid Fibers Using Ag Nanoparticles and Glycidyltrimethylammonium Chloride (GTAC) without the Aid of a Cross-Linking Agent. Polymers 2017, 9, 357. https://doi.org/10.3390/polym9080357
Kang C, Ahn D, Roh C, Kim SS, Lee J. Development of Synergistic Antimicrobial Coating of p-Aramid Fibers Using Ag Nanoparticles and Glycidyltrimethylammonium Chloride (GTAC) without the Aid of a Cross-Linking Agent. Polymers. 2017; 9(8):357. https://doi.org/10.3390/polym9080357
Chicago/Turabian StyleKang, Chankyu, Dajeong Ahn, Changhyun Roh, Sam Soo Kim, and Jaewoong Lee. 2017. "Development of Synergistic Antimicrobial Coating of p-Aramid Fibers Using Ag Nanoparticles and Glycidyltrimethylammonium Chloride (GTAC) without the Aid of a Cross-Linking Agent" Polymers 9, no. 8: 357. https://doi.org/10.3390/polym9080357
APA StyleKang, C., Ahn, D., Roh, C., Kim, S. S., & Lee, J. (2017). Development of Synergistic Antimicrobial Coating of p-Aramid Fibers Using Ag Nanoparticles and Glycidyltrimethylammonium Chloride (GTAC) without the Aid of a Cross-Linking Agent. Polymers, 9(8), 357. https://doi.org/10.3390/polym9080357

